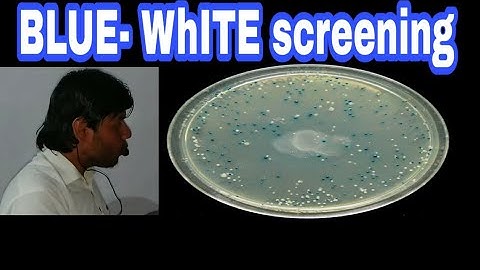
Screening part G (Blue-white screening) rDNA technology lecture 5

⬇ DOWNLOAD NOW
Kalau muncul iklan pop-up, tutup lalu klik tombol kembali
Download lagu Selectable markers: screening part A: rDNA technology lecture 5 secara gratis hanya untuk keperluan promosi. Dukung artis favorit kamu dengan membeli musik original di iTunes atau platform resmi lainnya.
 How do Antibiotic Resistance Genes function as selectable marker or helps in transformant selection?
How do Antibiotic Resistance Genes function as selectable marker or helps in transformant selection?
![Construction of a Plasmid Vector [HD Animation]](https://i.ytimg.com/vi/KRpik9mNRm0/hqdefault.jpg?sqp=-oaymwE9COADEI4CSFryq4qpAy8IARUAAAAAGAElAADIQj0AgKJDeAHwAQH4AZQFgALgA4oCDAgAEAEYWyA5KH8wDw==&rs=AOn4CLDGS4b5sH1VPBBG8kvP5RBCXW8LDw) Construction of a Plasmid Vector [HD Animation]
Construction of a Plasmid Vector [HD Animation]
 Role of Selectable Markers in rDNA Technology
Role of Selectable Markers in rDNA Technology
 introduction to Screening techniques: types: part B: recombinant DNA technology lecture 5
introduction to Screening techniques: types: part B: recombinant DNA technology lecture 5
Screening part G (Blue-white screening) rDNA technology lecture 5
Screening part G (Blue-white screening) rDNA technology lecture 5
 Molecular Cloning explained for Beginners
Molecular Cloning explained for Beginners
 Insertional inactivation (two antibiotic selectable markers) | Biotechnology | Khan Academy
Insertional inactivation (two antibiotic selectable markers) | Biotechnology | Khan Academy
 Selectable Markers for Synthetic Biology
Selectable Markers for Synthetic Biology